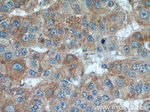
GPNMB Antibody in Immunohistochemistry (Paraffin) (IHC (P))

Search
Proteintech
GPNMB Polyclonal Antibody
{{$productOrderCtrl.translations['antibody.pdp.commerceCard.promotion.promotions']}}
{{$productOrderCtrl.translations['antibody.pdp.commerceCard.promotion.viewpromo']}}
{{$productOrderCtrl.translations['antibody.pdp.commerceCard.promotion.promocode']}}: {{promo.promoCode}} {{promo.promoTitle}} {{promo.promoDescription}}. {{$productOrderCtrl.translations['antibody.pdp.commerceCard.promotion.learnmore']}}
产品信息
20338-1-AP
已发表种属
宿主/亚型
分类
类型
抗原
偶联物
形式
浓度
规格
保存条件
运输条件
产品详细信息
Immunogen sequence: AKRFHDVLG NERPSAYMRE HNQLNGWSSD ENDWNEKLYP VWKRGDMRWK NSWKGGRVQA VLTSDSPALV GSNITFAVNL IFPRCQKEDA NGNIVYEKNC RNEAGLSADP YVYNWTAWSE DSDGENGTGQ SHHNVFPDGK PFPHHPGWRR WNFIYVFHTL G (22-181 aa encoded by BC011595)
靶标信息
The protein encoded by this gene is a type I transmembrane glycoprotein which shows homology to the pMEL17 precursor, a melanocyte-specific protein. GPNMB shows expression in the lowly metastatic human melanoma cell lines and xenografts but does not show expression in the highly metastatic cell lines. GPNMB may be involved in growth delay and reduction of metastatic potential. Two transcript variants encoding different isoforms have been found for this gene.
仅用于科研。不用于诊断过程。未经明确授权不得转售。